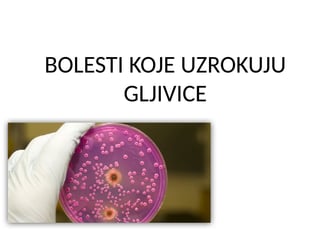
Bolesti koje uzrokuju gljivice

Bolesti koje uzrokuju gljivice
aspergilus
gljivične bolesti
histoplazmoza
PPTX · 18 str.
Pogledaj

